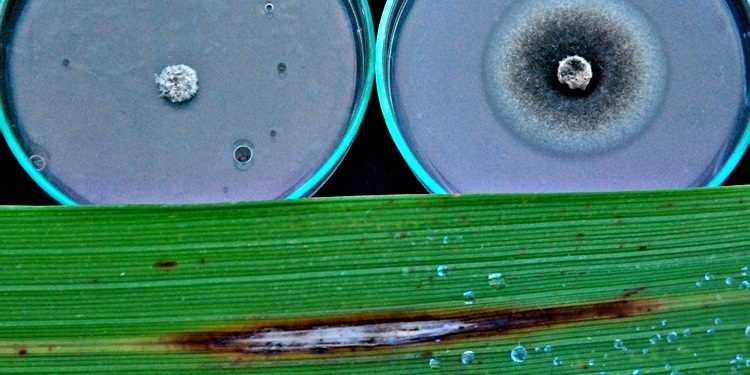
Arroz brusone

Os microrganismos benéficos são objeto de estudos dos pesquisadores da Embrapa e instituições parceiras, como a Universidade Federal de Goiás (UFG), que identificaram fungos e bactérias, denominados agentes biológicos promotores de crescimento, melhor eficiência às condições climáticas e indutores de resistência às principais doenças e pragas das culturas o arroz e do feijão.
O Rhizobium tropic e o Azospirillum brasiliense são dois exemplos de microrganismos vivos, conhecidos no meio agrícola pela capacidade de fixação de nitrogênio; o primeiro no feijoeiro e na soja, o segundo em arroz, milho e trigo, sendo ambos já utilizados pelos produtores.
Os testes realizados com as bactérias do gênero Rhizobium sp. e Azospirillum sp. pela equipe técnica da Embrapa Arroz e Feijão (GO) indicam um aumento de até 31% na produtividade das lavouras de feijão com a aplicação dos microrganismos, dando origem a novos bioprodutos para a agricultura, como os inoculantes promotores de crescimento.
Os bons resultados de produção com sustentabilidade ambiental na cultura do feijão indicam que o Rhizobium apresenta desempenho distinto ao de outras leguminosas, pois promove o crescimento vegetal, por meio da produção de hormônios, como o ácido indo I acético – AIA.
Com base no nitrogênio (N2) um dos principais nutrientes para o desenvolvimento das plantas, presente em 78% da atmosfera e que incrementa aumento de qualidade e produtividade do teor de proteína nos grãos de feijão.
Neste cenário, as bactérias benéficas a natureza são de grande importância agronômica, ambiental e econômica para os produtores, pois buscam captar este N2 não assimilável que estão na atmosfera e o transforma em uma forma assimilável pelas plantas, dispensando a adubação nitrogenada.
O processo é chamado de fixação biológica de nitrogênio e é considerado o mais importante processo biológico do planeta, depois da fotossíntese. As bactérias benéficas colonizam as células dentro dos nódulos radiculares das raízes da planta, convertendo o nitrogênio atmosférico em amônia (um processo denominado fixação do nitrogênio ou amonificação).
A associação desses microrganismos faz com que as plantas tenham o suprimento de nitrogênio fornecido, sem necessidade da adubação. Assim, além da redução nos custos de produção, ocorrem ganhos ambientais; o nitrogênio fornecido via insumos químicos é sujeito a perdas por lixiviação, em que contamina os recursos hídricos e por volatilização – emite o óxido nitroso, potente gás de efeito estufa.
Com o Azospirillum, sua função é atuar na potencialização de desenvolvimento da planta, principalmente raízes, resultando em melhores condições para que ela estabeleça simbiose com a fixação de nitrogênio: “associando maior volume radicular gerado pelo Azospirillum maior será a absorção de água e de nutrientes do solo, aumentando o crescimento da parte aérea e a produção de grãos”, diz Adriano Stephan Nascente, pesquisador da área de fitotecnia que vem desenvolvendo trabalhos com microrganismos benéficos, juntamente com outros pesquisadores da Embrapa Arroz e Feijão.
Existe, ainda, como benefício desses organismos, a mitigação de gases de efeito estufa, que gera uma economia equivalente a mais de 45 milhões de toneladas de gás carbônico (C02). Também os inoculantes com o Rhizospirilium tropici ou o Azospirillum brasiliense podem gerar níveis de produtividade 11% maior do que com a adubação nitrogenada, com média de produção acima de 3.200 quilos por hectare (ha).
Outros microrganismos nas culturas do arroz de terras altas e irrigado indicam que eles podem proporcionar maior desenvolvimento e produtividade das plantas. Estudos desenvolvidos em condições controladas e em campo mostraram que a Serratia sp. no arroz de terras altas e o Bacillus sp. no arroz irrigado foram os que apresentaram maiores produtividades das culturas.
No meio ambiente esses benefícios também se verificam pela diminuição de uso de fertilizantes químicos nas lavouras, enfatiza Adriano. Entre as culturas de grãos, se espera que o aumento da área cultivada com o uso de fixação biológica de nitrogênio (FBN) seja responsável por grande parte do que o governo espera em melhora ambiental, ou seja, uma redução das emissões de gases de efeito estufa (GEE) entre 36,1% e 38,9% até 2020.
Conhecer o potencial dos fungos e bactérias para a cultura do arroz, tanto de terras altas quanto para o irrigado, e os mecanismos que eles são capazes de beneficiar se torna imprescindível: “quando são desenvolvidos, os bioprodutos que são gerados a partir destas bactérias trazem uma economia significativa em gastos com fertilizantes nitrogenados e agrotóxicos; eles proporcionaram um incrementos em mais de 15% na produtividade de grãos do arroz de terras altas e irrigado, bem como reduz a adubação nitrogenada de 120 para 80 kg/ha”, ressalta Cristina de Fillippi.
Combate a doenças e pragas do arroz – A investigação sobre os gêneros Trichoderma, Cladosporium, Epicoccum e de bactérias (rizobactérias e actinomicetos), além do fungo micorrízico Waitea circinata, que vivem no solo ou na parte aérea da planta, em interação com as raízes e folhas do arroz, sem causar danos evidenciam que esses gêneros e espécies são benéficos à cultura vegetais.
Os fungos e bactérias são reconhecidamente os antagonistas de duas das principais doenças no arroz: a brusone e a queima-da-bainha; eles combatem, ainda, insetos-pragas como lagartas (Spodoptera jrugiperda), os percevejos do grão (Oebalus poecilus), do colmo (Tibraca limbativentris) e de brocas (Diatra saccharalis e Rubela albinella), presentes no sistema produtivo de terras, nas várzeas tropicais e subtropicais do país.
Outro fungo, o Cordyceps javanica, é extremamente patogênico à mosca branca, uma das principais pragas de diversas culturas agrícolas nacionais e seu uso irá proporcionar a redução significativa do uso de agrotóxicos nas culturas agrícolas, principalmente do feijão-comum.
Efeitos dos bioagentes na agricultura – A utilização de insumos biológicos vem ocorrendo com maior frequência na agricultura, substituindo os insumos químicos industrializados que podem causar:
• Diminuição da eficiência de cultivares resistentes a doenças por utilizarem produtos químicos sintéticos;
• Dissociam da sociedade processos de produção sustentáveis para o meio ambiente e por produtos livres de resíduos químicos;
• Menores resultados promissores de pesquisa científica, que tornam os produtos de origem microbiana (bioprodutos) menos competitivos que os produtos químicos sintéticos. Segundo o Sistema de Agrotóxicos Fitossanitários (Agrofit) do Ministério da Agricultura, Pecuária e Abastecimento (Mapa), em 2014 foi registrada a maior quantidade de agrotóxicos comercializados no Brasil.
Entre 2007 e 2014, esse quantitativo passou de cerca de 623.353.689 quilos para 1.552.998.056 quilos, um aumento equivalente a 149,14%. Por sua vez, a área plantada (representada pela soma da lavoura temporária e da lavoura permanente) aumentou de 62.338.730 hectares para 76.246.588 hectares (22,31%), segundo dados do Sistema de Recuperação Automática (Sidra) do Instituto Brasileiro de Geografia e Estatística (IBGE).
No que se refere à comercialização de agrotóxicos por hectare de área plantada, o Brasil registrou 16,87 kg/ha (considerando as variáveis do banco Agrofit: cliente, venda e revenda). Para Adriano Nascente os microrganismos proporcionaram incrementos significativos nas trocas gasosas e produção de biomassa de cultivares de arroz irrigado: “apesar dos benefícios proporcionados pelo uso de microrganismos benéficos na agricultura, como a redução na adubação nitrogenada e aumento da produtividade de grãos, ainda existem poucos estudos no Brasil sobre o seu uso na cultura do arroz irrigado na região tropical”.
O pesquisador considera que a atuação conjunta do Rhizobium e Azospirillum é uma solução viável na redução dos custos de produção e nos incrementos da produtividade das culturas.

Startup de microrganismo para a lavoura – O engenheiro agrônomo, Alan Carlos Alves de Souza e o biólogo Fábio José Gonçalves, foram bolsistas da Embrapa Arroz e Feijão, durante os cursos de mestrado e doutorado, tendo como orientadora da pesquisa, a fitopatologista Marta Cristina. Alan desenvolveu estudos sobre o controle de doenças do arroz com uso de microrganismos benéficos; já, Fábio José, destinou o trabalho em genética e melhoramento em plantas, especificamente, com estudo em brusone do arroz e fusariose em feijão.
Neste período eles sempre trabalharam com microrganismos, especificamente isolados de bactérias pré-selecionadas em ensaios realizado em Casa de Vegetação da Embrapa; foram identificados diversos benefícios para a cultura do arroz, como a promoção de crescimento, testes para aumento da produtividade e combate às principais doenças do arroz como a brusone.
Depois de finalizado o curso de doutorado, em 2013, Fabio se dedicou a criar o próprio laboratório, voltado a análises de sementes. Em 2018, foi a vez de Alan Carlos, que concluiu a tese de doutorado na UFV. A partir desse momento, ele procurou o colega de estágio na Embrapa e propôs a parceria, com o startup, voltado ao desenvolvimento de produtos biológicos para a agricultura, a base de isolados (bactérias e fungos), como Bacillus sp. e Pseudomonas sp., negociados com a Embrapa: “Com a pesquisa desenvolvida com os isolados durante o mestrado e doutorado produzi muitos artigos e estudos voltados aos microrganismos; passei a me dedicar em desenvolver um produto com os mesmos isolados de bactérias; eu e o Fábio sabíamos que estes microrganismos tinham potencial para serem utilizados em diversas culturas agrícolas”, lembra Alan.
Inicialmente, os ex-bolsistas da Embrapa, desenvolveram pesquisas com o arroz; com o avanço dos es Alan.tudos passaram a avaliar o material em outras culturas, como a soja, o feijão e o milho, as braquiárias e também pesquisas sobre aplicabilidade em frutíferas e hortaliças. O resultado da pesquisa acabou gerando dois biofertilizantes para a lavoura: um voltado ao aumento de biomassa de raízes e folhas de plantas, com maior absorção de nutrientes com a fixação de N2 e a promoção de crescimento de raízes em hortifrúti, leguminosas, braquiárias e plantas ornamentais; o segundo biofertilizante atua na promoção de crescimento, estímulo ao aumento e perfilhamento das culturas, com alta eficiência produtiva.
O contrato da startup dos produtos já foi elaborado e apresentado ao setor responsáveis da Embrapa para aprovação; no momento, a proposta se encontra em análise pelo Núcleo de Inovação Tecnológica (NIT) da Empresa. Após esta fase os inoculantes serão submetidos a equipe técnica do Ministério da Agricultura, Pecuária e Abastecimento (Mapa) para a liberação do registro; concluída a etapa, os biofertilizantes estarão aptos para a comercialização no mercado nacional e internacional: “O produto tem como base microrganismos multifuncionais sendo, portanto, indicado para o controle de doenças radiculares, e doenças na parte aérea da planta, como as manchas foliares, entre outras aplicações”, destacou Fábio José.
No mercado, atualmente são comercializados produtos para culturas de gramíneas e leguminosas, mas poucos estão disponíveis a hortaliças e as frutíferas. Nessa perspectiva, a linha de pesquisa, investigada pelo startup de Fábio e Alan está permitindo o uso dos microrganismos em novas formulações que foram testados primeiramente em condições controladas em laboratório e, posteriormente, em experimentos conduzidos em diferentes sistemas de produção.
Menor impacto ambiental – Com as alterações climáticas e o impacto do crescimento populacional ao meio ambiente está gerando maior conscientização da sociedade que, cada vez mais, busca alternativas que causem menor impacto.
A produção de alimentos por meio do controle biológico e o desenvolvimento de biofertilizantes naturais têm se tornado uma realidade eminente na vida das pessoas. Em informações apresentadas pela Associação Brasileira das Empresas de Controle Biológico (ABCBio), só em 2019, foram aprovados pelo Mapa, cinquenta e dois produtos biológicos de controle que, somando aos outros produtos já registados, movimentou R$ 464,5 milhões, um crescimento de 77% em relação ao ano anterior.
A estimativa de crescimento anual dos produtos biológicos é de 25%, só no Brasil, superando a expectativa de 17% para o mercado global. Isto significa um incentivo para maiores investimentos no desenvolvimento de tecnologias sustentáveis, tendo nos produtos biológicos maior atenção para os próximos anos, em todo o planeta.
Hélio Magalhães (4911 DRT MG)
Embrapa Arroz e Feijão
O artigo foi publicado originalmente em Embrapa.

Discussão sobre este post